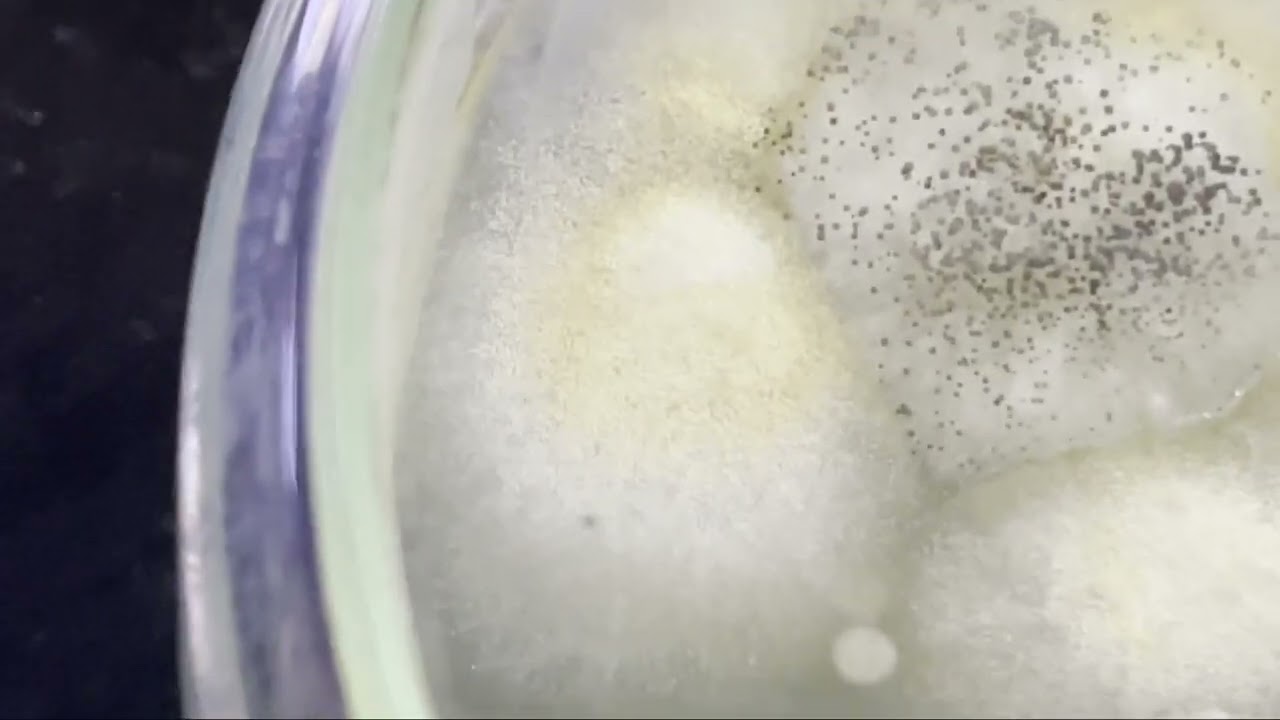
Fungi growth | White colony Black spore

cultivation of filamentous fungi
cultivation of fungi
fungi growth
fungi media
mushroom cultivation
types of fungi media
isolation of fungi in random sample
isolation fungi in soil , bread , mushroom , wood
identification of fungi
mounting of fungi
classification of fungi
microscopy of fungi
media preparation of fungi
how to isolate fungi
how to isolate fungus in soil
how to prepare fungi media
fungus spore
huphae , mycelium , septum
SDA media
PDA media
ROSE BENGAL media
#fungi
microbiology status
microbiologist
microbiology day life
msc microbiology students
bsc microbiology students
science student
#microbiology
pour plating
streak plate
autoclave plate
media composition
#microhive
____ Fungi examples ____
Ascomycota
Trichophyton rubrum , Penicillium , Candida albicans , Saccharomyces cerevisiae , Xanthoria parietina
Basidiomycota :
Agaricus Bisporus , Amanita phalloides , Hemileia vastatrix , Lycoperdon perlatum , Psilocybe cubensis
Chytridiomycota :
Batrachochytrium dendrobatidis , Synchytrium endobioticum , Olpidium brassicae , Polyphagus euglena , Rhizophydium harderi
Glomeromycota :
Gigaspora margarita , Geosiphon pyriformis , Scutellospora persica , Acaulospora scrobiculata , Gigaspora gigantea
Zygomycota :
Rhizopus stolonifer , Rhizopus oligosporus , Pilobolus umbonatus , Mucormycetes , Syzygites megalocarpus
Etc. : Yeast , mould , aspergillus , penicillium , mushroom , Hamigera, Paecilomyces, Rasamsonia, Sagenomella, Talaromyces, Trichocoma,
#fungus #morphology #microscope #lectophenol #picricacid #biology #science #biotechnology #biochemistry #medicine #microbiologist #medical #laboratory #lab #molecularbiology #microscope #bacteria #microbiologia #pathology #neet #biotech #genetics #sda #pda #cellbiology #research #doctor #rosebengal #microscopy #chemistry #biologystudent #pharmacology #scientist #physiology #dna #anatomy #microbiologylab #mbbs #virology #fungimedia #bacteriology #pharmacy #medicalstudent #biotechnologist #nature #biologymemes #immunology #biologia #lifescience #surgery #health #virology #biotechnologystudent #covid #biologist #zoology #biologynotes #bhfyp #pharmacist #micro #study #lablife #biologylab #bio #cell #microbes #lifesciences #virus #medico #fungi #algae #musroom #bsc #msc #microbiologystatus #net #csirnet #ugcnet #netjrf #microbiologyvlog

Информация по комментариям в разработке